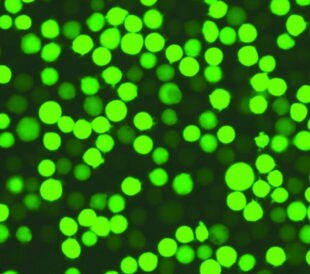
reporter-gene-assays-title

みなさんは培養細胞を扱う中で、トランスフ...

培養細胞におけるsiRNAの導入を最適化するTipsトップ10【前編】
続きを読む 培養細胞におけるsiRNAの導入を最適化するTipsトップ10【前編】

みなさんは培養細胞を扱う中で、トランスフ... by LATB Staff / 04.26.2018

RNAのトランスフェクションは、RNAを細胞に導... by LATB Staff / 02.16.2017

古典的なトランスフェクション技術は、当初... by LATB Staff / 02.02.2017

トランスフェクションの成功には多くの要素... by LATB Staff / 01.24.2017
レポーター遺伝子とは、トランスフェクショ... by LATB Staff / 01.10.2017

これまでトランスフェクションにおいて、核... by LATB Staff / 01.04.2017

機能解析のためのタンパク質発現や生産、特... by LATB Staff / 12.19.2016